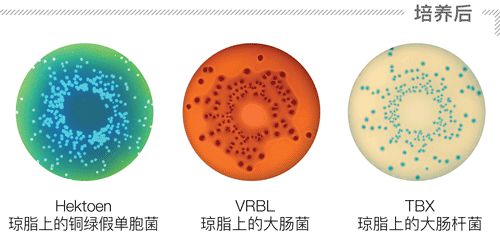
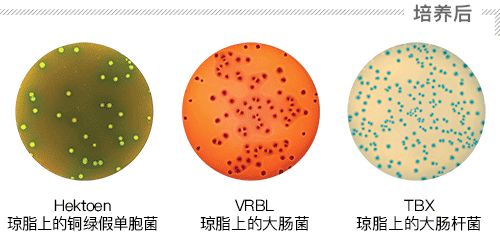

保证可溯源
easySpiral Pro 是一台自动培养皿接种仪。它可接受从100到 1x107CFU / mL的任何样品无需稀释,直接接种到一个培养皿上。可保证溯源性并且接种体积可以通过USB连接编辑。
可追溯和可编辑体积
接种模式: 指数, 均一, 循环
计数范围: 从100到1x107 CFU/mL
接种周期时间: 25 秒
螺旋方法
使用螺旋方法,可以增加分析能力:无需中间稀释,在单个培养皿上完成标准化从 100 到1x107 CFU/mL 的自动接种!

手工方法需要重复操作:至少需要4次稀释和4次接种,才能获得一个好的,可读的培养皿。

用这种方法,只需要一个培养皿就可以分析了。
耗材:节省高达75%
easySpiral的指数接种模式可减少您的耗材使用量和体积浪费量,您还将享受更多的实验室空间。接种仪无需特定的耗材。
一个接触接种
简单且快速地在90和150毫米培养皿上接种。从3种接种模式选择:指数,均一和循环。
指数模式
指数模式是一种表面浓度递减的表面接种。接种体积可选50 µL, 100 µL, 200 µL或自定义编辑体积 。
获得100至1x107 CFU/mL的可计数培养皿。

均一模式
均一模式是一种均匀涂布的表面接种。接种体积可选50 µL, 100 µL, 200 µL或自定义编辑体积。因为在培养皿边缘无菌落,所以菌落计数很容易进行。

高精度玻璃注射器
玻璃注射器的精度为0.5%。 比普通移液器精度更高,无需进行移液器校准。

自动消毒
溢出技术清洗系统和接种针消毒。如果消毒剂液体不足,指示灯会亮起。
专利
高速自动化
快速旋转的手臂可自我调节以适应所有类型的琼脂,避免接种污染的可能性。可以在25秒内完成一次接种(消毒+取样+接种)。
专利

使用dataLink确保可追溯性
使用dataLink和dataLink pro,可实现样品从接种到自动菌落计数的全程追溯.
参数标签贴在培养皿边缘。进一步优化菌落计数。


紧凑和人力工程学

简单安全的连接

长独立

USB 可编辑 体积
应用
easySpiral Pro 接种仪 用于微生物实验中培养皿的接种。螺旋接种法 通常用于检测质量标准高于 100 CFU/g 的微生物。ISO 4833-2 规定了使用这种技术来检测菌落总数。均一模式相当于均匀的接种在培养皿表面,允许对质量标准低于 100 CFU/g 的微生物进行计数。



